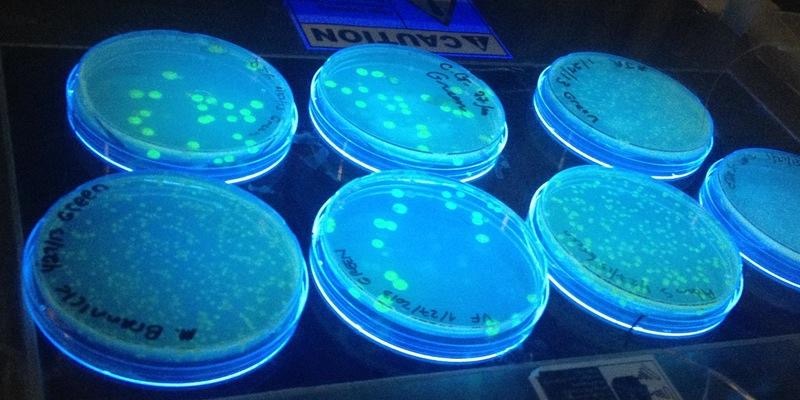

RSVP here.
Synthetic biology endeavors to program life as we would program computers—only with DNA instead of machine code. For the past 20 years, synthetic biologists have reshaped what living things do by rewriting their DNA. They’ve turned living cells into biosensors, fuel and medicine producers, and far more.
In this workshop, you will learn the fundamentals of synthetic biology in a hands-on way. You’ll learn how Biobricks work, how DNA can be made into a programming language, and engineer bacteria to glow.
This workshop complements a panel discussion taking place at Data & Society on March 16th entitled Synthetic Biology—Programming with DNA. Panel attendance is not a prerequisite, but is recommended.
ABOUT THE SERIES
The Biotech Futures Talk + Lab Series explores the implications and ways in which biology is becoming a data science. Each talk is paired with a 3-4 hour lab workshop at Genspace for Data & Society and Genspace community members to demonstrate how these themes become realized in the lab.
Contact Alison Irvine ([email protected]) for more details.
INSTRUCTOR:
JULIE WOLF
Julie Wolf spent her research career focused on medical mycology and infectious disease, studying fungi that make you sick and the genes they need to do so. Broadly interested in microbiology and scientific communication, she has mentored the Genspace iGEM team since 2012 and taught the Biotech Crash Course since 2015. She currently works as the Science Communication Specialist for the American Society for Microbiology. Follow her on Twitter for more science highlights at @JulieMarieWolf.
PRESENTED BY:
Genspace is a nonprofit organization dedicated to promoting science literacy through citizen access to biotechnology. It provides educational outreach, cultural events, and a platform for science innovation at the grassroots level. Genspace values cross-disciplinary practices and the significance of creating an environment in which designers, artists, and scientists can exchange new methodologies and practices, and provide a platform for collaborations, innovations, and critical dialogue.
Data & Society is a research institute in New York City that is focused on social, cultural, and ethical issues arising from data-centric technological development. To advance public understanding of the issues, Data & Society brings together diverse constituencies, hosts events, does directed research, creates policy frameworks, and builds demonstration projects that grapple with the challenges and opportunities of a data-soaked world. Data & Society weaves together researchers, entrepreneurs, activists, policy creators, journalists, geeks, and public intellectuals to debate and engage one another on the key issues.